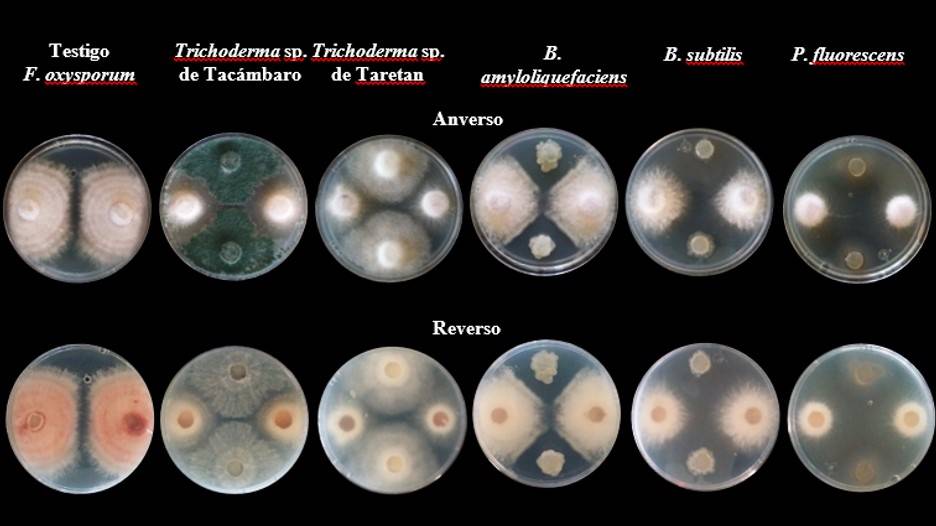

Introducción
México destaca como productor mundial de berries, siendo la zarzamora (Rubus sp.) la más prominente (Ricárdez-Luna et al., 2016). Michoacán aporta significativamente el 93.3% de la producción de zarzamoras (SIAP, 2021). Aunque esta fruta se adapta bien a condiciones templadas, sufre restricciones en la producción y comercialización debido a Fusarium oxysporum, causante de la marchitez en plantaciones de zarzamora en California y México (Gordon et al., 2017).
Un nuevo linaje de F. oxysporum, identificado recientemente, ha emergido como responsable de la enfermedad, convirtiéndose en una amenaza devastadora en México, especialmente con expresión epidémica severa en la variedad Tupy en plantaciones comerciales (Hernández-Cruz et al., 2020).
Debido a los riesgos ambientales y de salud que el uso extensivo de fungicidas y fumigantes sintéticos plantea (Guédez et al., 2009; Vásquez-Ramírez, 2017), es imperativo reducir el uso de plaguicidas químicos que afectan el ecosistema (Villa et al., 2005). La aplicación de microorganismos antagonistas emerge como una alternativa indispensable, no solo para el control fitopatológico sino también para mejorar la tolerancia al estrés en las plantas (Guédez et al., 2008; Tian et al., 2018).
Dada la urgencia de enfoques con menor impacto ambiental, este trabajo tiene como objetivo evaluar la eficacia de microorganismos antagonistas en el manejo de la enfermedad de marchitez en la zarzamora.
Materiales y métodos
Recolecta, aislamiento e identificación
En el municipio de Tocumbo, en 2022, se llevó a cabo un muestreo dirigido a plantas sintomáticas de marchitez en un huerto de zarzamora ‘Tupy’ (19° 38’ 21.5” latitud norte y 102° 29’ 02.9” longitud oeste) a 1 300 msnm. La planta, de segundo año y manejo convencional, fue cultivada a cielo abierto. Se siguieron técnicas fitopatológicas de Agrios (2005) y Trigiano et al. (2004). Las raíces sintomáticas se sembraron en medio de cultivo ½X papa dextrosa agar (PDA) e incubaron a temperatura ambiente en obscuridad, puntas de hifa. Se obtuvieron cultivos monospóricos en medio de cultivo agar Spezieller Nührstoffarmer (SNA) y se almacenaron a -70 °C en glicerol 25% estéril.
Para la identificación se utilizaron las claves de Barnett y Hunter (1998); Leslie y Summerell (2006), comparando morfológicamente con preparaciones fijas. Se realizó una caracterización cultural en medio 1XPDA y se inocularon 20 μl de la suspensión de conidios en glicerol 25%. Se registraron características morfológicas y culturales, incluyendo tipo y espesor del micelio, color de la colonia, pigmentación del agar, presencia y color del esporodoquio, presencia de clamidosporas, y posible presencia de hifas enrolladas a los 15, 30 y 60 días.
La caracterización morfológica adicional se realizó en medio hojas de clavel agar (CLA), se inocularon 5 μl de la suspensión y midió el largo y ancho de 50 macroconidios y 50 microconidios de cada aislamiento. Se determinaron características como forma, tipo de pie y célula apical en macroconidios y forma, disposición y tipo de fiálide en microconidios, junto con la presencia y disposición de clamidosporas e hifas enrolladas a los 10 días.
Para la tasa de crecimiento, se inocularon 5 μl de la suspensión en medio SNA sin papel, incubando por siete días a 25 °C en oscuridad. Se transfirió un disco de 6 mm de diámetro al centro de una caja de Petri con medio PDA, se incubó por 72 h y se registró la tasa de crecimiento (mm). El análisis de varianza se realizó con el programa R versión 3.5.1 (R Core Team, 2020) y la interfaz R Studio versión 1.1.463 (Rstudio Team, 2020), con seis repeticiones y dos repeticiones del experimento.
Pruebas de patogenicidad
De acuerdo con Dhingra y Sinclair (1985), en plántulas sanas de zarzamora provenientes de un vivero en Zirimícuaro, Michoacán, crecidas en granzón como sustrato, se inocularon 100 ml en suspensión 1 x 10⁶ conidios ml-1. Las plantas se evaluaron cada 15 días, observando desde los primeros síntomas hasta la total marchitez característica de la enfermedad. Se corroboraron los postulados de Koch.
Bioensayo in vitro
Se realizaron pruebas de confrontación in vitro entre antagonistas (Trichoderma nativos de Tacámbaro y Taretan, Bacillus subtilis, Bacillus amyloliquefaciens y Pseudomonas fluorescens) y el patógeno mediante el método de confrontación por cuadrantes, en placas Petri con 20 ml de medio de cultivo PDA. La placa se dividió en cuadrantes, depositando discos (10 mm de diámetro) del patógeno y antagonista en extremos opuestos, el tratamiento control consistió solo en el patógeno sin antagonista.
Se utilizó un diseño experimental completamente al azar con seis repeticiones, midiendo el crecimiento radial cada 24 h. Las mediciones del crecimiento radial del patógeno (CR mm) en interacción con los antagonistas y del testigo (patógeno) aislado determinaron el efecto antagonista in vitro. Se realizó un análisis de varianza del crecimiento diario durante ocho días, con la separación de medias de Tukey (0.05). Los análisis se realizaron mediante el programa R versión 3.5.1 (R Core Team, 2020) y la interfaz R Studio versión 1.1.463 (Rstudio Team, 2020). Basados en los resultados del ensayo in vitro, se confrontaron los antagonistas en condiciones de invernadero para evaluar su eficiencia in vivo en el control del patógeno.
Bioensayo en invernadero
En plantas sanas de zarzamora Tupy de cuatro meses de vivero comercial en Zirimícuaro, Michoacán, se aplicaron preventivamente y como control 100 ml de una solución de 1 x 10⁶ UFC ml-1 de Bacillus subtilis y Pseudomonas fluorescens, y 100 ml de una solución de 1 x 10⁶ conidios ml-1 de Trichoderma sp., nativo de Tacámbaro, de forma individual y combinada, generando 14 tratamientos bajo un diseño de bloques al azar. Cada unidad experimental constó de 6 repeticiones, las plantas se colocaron en granzón estéril como sustrato.
Los tratamientos preventivos se aplicaron dos semanas antes de inocular las plantas con una solución de conidios de 1 x 10⁶ conidios ml-1 de patógeno. En los tratamientos de control, la inoculación del patógeno precedió a los antagonistas por dos semanas, utilizando la misma concentración de esporas. Se establecieron testigos para cada caso.
Se evaluaron las variables de incidencia de amarillamiento y marchitez de follaje, determinando el porcentaje de follaje con síntomas de la enfermedad, y se evaluó de acuerdo con la siguiente fórmula:
La severidad de la enfermedad se midió en una escala del 1 a 100% según el daño foliar. La altura de la planta se comparó con las plantas sanas. Se registraron peso, longitud y necrosis de la raíz, estableciendo porcentajes de pudrición en una escala del 1 al 100%. Los datos se transformaron con la función arcoseno para el análisis.
Se realizaron análisis estadísticos con el programa R versión 3.5.1 (R Core Team, 2020) y la interfaz R Studio versión 1.1.463 (Rstudio Team, 2020) de cada variable para un diseño completamente al azar y la separación de medias de Tukey (0.05).
Resultados y discusión
De los aislamientos realizados se obtuvo un aislado, que por comparación de sus características morfológicas pertenece al género Fusarium.
Características culturales
La colonia en PDA tuvo crecimiento radial, micelio abundante, algodonoso, flocoso, aéreo de margen entero. De color blanco por el anverso y de blanco a rosado, violeta claro y violeta oscuro por el reverso con forme envejeció la colonia (Figura 1).

Figura 1 Caracterización cultural de los aislados de Fusarium en los medios de cultivo: PDA, SNA y CLA.
La temperatura, oscuridad y el medio de cultivo son factores importantes para la formación de pigmentos en este género. El medio PDA por su contenido de carbohidratos permite desarrollo y expresión ideales del cultivo como la forma, color, pigmentación del medio y crecimiento (Leslie y Summerell, 2006).
Características morfológicas
En medio PDA se observaron microconidios elípticos, en falsas cabezas, sin septos, raramente con un septo, clamidosporas intercaladas. En medio SNA, microconidios uniformes, en monofialides cortos, con micelio aéreo. La formación de macroconidios solo se observó en el medio de cultivo CLA, de forma casi recta, con tres septos, curvados apenas en las puntas, delgados, con célula apical curva y basal en forma de pie con tres septos (Figura 2).
Tasa de crecimiento
La tasa osciló entre 28 a 30 mm a las 72 h a 25 °C y aunque es un carácter secundario, tradicionalmente en medio PDA y dejado crecer por tres días a 25 o 30 °C, permite distinguir las especies de rápido o lento crecimiento (Leslie y Summerell et al., 2006). Las características de la colonia en los medios de cultivo PDA, SNA y CLA, así como la tasa de crecimiento, coinciden con lo señalado por Leslie y Summerell (2006) para la especie Fusarium oxysporum.
Pruebas de patogenicidad
Los síntomas se presentaron a los dos meses de la inoculación, iniciaron con amarillamiento y flacidez en las hojas, de la base de la planta, marchitando la planta a los cinco meses de la inoculación. Las raíces mostraron necrosis y decoloración marrón de los tejidos del xilema. El reaislamiento de las raíces confirmó la presencia del Fusarium oxysporum inoculado. Las plantas sin inocular se mantuvieron sin la presencia de síntomas (Figura 3).
Bioensayo in vitro
Los resultados demostraron variación significativa entre tratamientos. Desde el cuarto día, los efectos de Trichoderma sp., Tacámbaro, Trichoderma sp., Taretan y B. Subtilis fueron estadísticamente similares y superiores a B. amyloliquefasciens y P. fluorescens en la inhibición del crecimiento radial (CR) de Fusarium. Al octavo día, P. fluorescens mostró una disminución del CR del 78%, mientras que Trichoderma sp., Tacámbaro, Trichoderma sp., Taretan y B. subtilis registraron una disminución de 71%, 68% y 65%, respectivamente (Figuras 4 y 5).
Figura 4 Anverso y reverso de la confrontación por cuadrantes de Fusarium oxysporum con cada uno de los tratamientos antagonistas en el día ocho.

Figura 5 Comparación de medias (Tukey, 0.05) del crecimiento radial de Fusarium oxysporum durante ocho días.
Microorganismos como P. fluorescens, B. subtilis y ambas especies de Trichoderma, destacados por su eficacia en el control de Fusarium spp. y F. oxysporum en entornos controlados, han sido respaldados por estudios previos (Guerra et al., 2011; Tejera-Hernández et al., 2011; Guédez et al., 2012; Mejía-Bautista et al., 2016; Boughalleb-M’Hamdi et al., 2018).
El biocontrol con Trichoderma se atribuye a la producción de enzimas con actividad antifúngica, afectando el micelio de F. oxysporum por penetración y lisis (Martínez et al., 2013). La competencia por espacio y nutrientes también influyen (Infante et al., 2009). En el tratamiento con Trichoderma sp. de Tacámbaro, se observó un parasitismo inicial del patógeno, corroborando hallazgos anteriores con T. viride contra P. infestans (Bouziane et al., 2016).
Por otro lado, el antagonismo de P. fluorescens y B. subtilis, podría atribuirse a la antibiosis, competencia por recursos e inducción de resistencia sistémica. Además, de la producción de enzimas que degradan la pared celular y compuestos orgánicos volátiles, fitoalexinas y sideróforos (Cornelis et al., 2008; Bhattacharyya y Jha, 2012; Singh y Singh, 2013).
Bioensayo en invernadero
El amarillamiento y marchitez en las plantas de zarzamora inoculadas con F. oxysporum y con los antagonistas mostraron variación significativa. Los tratamientos preventivos con B. Subtilis (37.65), Trichoderma sp. (33.64%), P. fluorescens (42.32%) y el consorcio de los agentes antagonistas (37.46%) así como P. fluorescens (41.97%) como control, mostraron ser estadísticamente iguales, disminuyendo la incidencia comparados con el testigo inoculado con Fusarium que tuvo 100%; el tratamiento preventivo con Trichoderma sp., redujo la incidencia en un 66.36% (Figura 6).

Figura 6 Comparación de medias y porcentaje de severidad de los síntomas foliares en plantas de zarzamora inoculadas con F. oxysporum. P= preventivo y C= control.
Los tratamientos control con el consorcio de agentes antagonistas y con Trichoderma sp., se comportaron estadísticamente igual al testigo, con 98.97% y 96.69% de amarillamiento y marchitez. El tratamiento sin inocular y los inoculados con los antagonistas B. subtilis, Trichoderma sp., P. fluorescens solos o en consorcio no presentaron incidencia alguna.
De manera preventiva cada antagonista disminuyó el porcentaje de incidencia, coincidiendo con Acosta-González et al. (2018), quienes probaron agentes de control biológico comerciales y nativos en la incidencia de la marchitez de zarzamora por Fusarium y reportaron que cepas de Trichoderma, Pseudomonas fluorescens y complejos bacterianos mostraron resultados positivos al disminuir el porcentaje de incidencia. Trichoderma de forma preventiva disminuyó la severidad del amarillamiento en un 61.73%, tal como lo reportaron Rebollar y Silva (2019), en condiciones de invernadero para la marchitez de zarzamora.
La elevada incidencia de marchitez en el consorcio de antagonistas como control podría atribuirse a las complejas interrelaciones entre microorganismos en la interfaz suelo-planta-microorganismos-ambiente. Trichoderma y Pseudomonas suelen depender de estos factores para manifestar sus efectos beneficiosos. Sin embargo, en la interacción de estos tres tipos de microorganismos, pueden surgir efectos sinérgicos que amplifiquen los beneficios o, por el contrario, que no generen ningún efecto apreciable (Cano, 2011).
El tratamiento inoculado con Trichoderma sp. y el tratamiento preventivo, ambos estadísticamente iguales, exhibieron el mayor aumento en la altura de las plantas, semejando hallazgos previos de Ruiz-Cisneros et al. (2018) (Figura 7). Trichoderma genera metabolitos secundarios que influyen en el crecimiento y desarrollo de las plantas (Contreras-Cornejo et al., 2016). Además, puede activar genes relacionados con la defensa de las plantas, aumentando el nivel de ergosterol y favoreciendo un crecimiento más rápido en el suelo, explicando así sus efectos positivos en el crecimiento y defensa de las plantas (Mayo et al., 2015).

Figura 7 Aspecto de las plantas de zarzamora al finalizar las pruebas. A) planta sana; B) testigo P-B. subtilis; C) testigo Trichoderma sp.; D) P-B. subtilis; E) P-Trichoderma sp.; F) P-P. fluorescens; G) P-consorcio; H) testigo Fusarium oxysporum; I) testigo P. fluorescens; J) testigo consorcio; K) C-B. subtilis; L) C-Trichoderma sp.; M) C-P. fluorescens; y N) C-consorcio.
Las raíces de las plantas de zarzamoras del tratamiento sin inocular y los testigos inoculados con B. subtilis, Trichoderma sp., P. fluorescens y el consorcio de antagonistas mostraron un ligero porcentaje de necrosis radicular, se hicieron aislamientos de éstas descartándose la presencia de patógenos. Esta necrosis pudo ocasionarse por exceso de agua en el sustrato, el oxígeno escasea, provocando asfixia y posterior pudrición de raíces.
En los tratamientos inoculados con Fusarium, preventivos o de control, B. subtilis y Trichoderma sp., fueron estadísticamente iguales con medias de porcentaje de necrosis de 29.84% como en el caso del tratamiento preventivo P. Fluorescens. En comparación, el tratamiento de control con el consorcio de antagonistas y el testigo exhibieron estadísticas similares y los mayores porcentajes de necrosis (Figura 8).

Figura 8 Comparación de medias (Tukey, 0.05) del porcentaje de necrosis presente en la raíz de plantas de zarzamora. P= preventivo; C= control.
La eficiencia al disminuir el porcentaje de necrosis con el tratamiento preventivo de P. fluorescens podría deberse a su capacidad de colonizar la rizósfera de las plantas y presentar actividad antagónica hacia diversos patógenos (Perotti et al., 2005) al ser capaces de quelar el hierro haciéndolo menos disponible para los patógenos u otros microorganismos (Susan y Castiel, 2005). Esto coincide con Guerra et al. (2011), quienes reportaron cepas de P. fluorescens eficientes para el control de F. oxysporum en condiciones controladas y de invernadero.
Los tratamientos de control y preventivo con Trichoderma sp. disminuyeron el porcentaje de necrosis radicular, ya que al colonizar la rizósfera, cualquier patógeno que atraviese esa protección, es destruido por el hiperparasitismo que posee, además de actuar como barrera para prevenir la entrada de patógenos a las raíces (Gómez et al., 2013).
Conclusiones
Se identificó por sus caracteres morfológicos y culturales aFusarium oxysporum agente causal del amarillamiento y marchitez en plantas de zarzamora. Las cepas de Trichoderma, Bacillus y P. fluorescens presentaron in vitro capacidad antagónica mayor al 50% frente a F. oxysporum, P. fluorescens destacó con un notable 78% de inhibición en el crecimiento radial.
En invernadero, los tratamientos preventivos exhibieron notable capacidad antagónica, al reducir la incidencia del marchitamiento en más del 57%. Trichoderma sp. destacó con una disminución superior al 66% y un incremento de altura superior al 50%. B. subtilis y P. fluorescens como control también mostraron reducciones superiores al 45%.
En los tratamientos preventivos y de control B. subtilis y Trichoderma sp., redujeron la necrosis radicular en más de 49%, destacó el tratamiento preventivo con Trichoderma sp., con una disminución superior al 62%. La aplicación preventiva de los microorganismos antagonistas mostró mayor eficacia en la prevención del amarillamiento y marchitez de la zarzamora en comparación con su aplicación como control.











 texto en
texto en 




